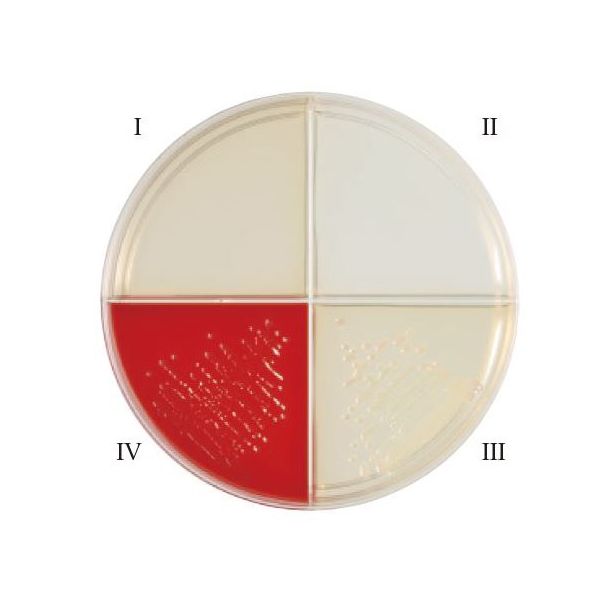

¥6,784(税込)
/¥6,168(税抜き)
販売単位:1個(10本)
お申込番号:AUP4289
メーカー:日本ベクトン・ディッキンソン
/型番:251142
/JANコード:0382902511427
/アズワン/ナビス品番:63-6527-71
| お申込番号 | AUP4289 |
|---|---|
| メーカー | 日本ベクトン・ディッキンソン |
| 型番 | 251142 |
| JANコード | 0382902511427 |
| 販売単位 | 1個(10本) |
| 価格 | ¥6,784(税込) /¥6,168(税抜き) |
直送品のため、以下の点にご注意ください。
- こちらの商品は沖縄県・離島・その他一部地域・山間部で配送追加料金が発生します。地域等によっては、お届けできない場合もございますのでご了承ください。ご注文後、お届け不可の場合は、アスクルよりご連絡させて頂きます。
- この商品には、アスクル発行の納品書が同梱されていない場合があります。アスクル発行の納品書をご希望のお客様は、商品到着後、本サイト上のご利用履歴よりPDFファイルにて印刷することが可能です。
- アスクルのダンボールもしくは袋でのお届けではありません。
- お客様のご都合によるご注文後の変更・キャンセル・返品・交換はお受けできません。
- 商品のご注文後に商品がお届けできないことが判明した際には、ご注文をキャンセルさせていただくことがあります。
- ご注文後に一時品切れが判明した場合は、入荷次第のお届けとなります。

この画像は代表画像です。詳細は仕様をご確認ください。
¥6,784 (税込)
/ ¥6,168 (税抜き)
商品詳細
返品不可
お客様のご都合による返品はお受けできません。
直送品
出荷元より直接お届けする商品です。一般商品とは別便でお届けとなります。レジ画面に表示されるのはお届け日の目安です。こちらの商品はお客様都合による返品をお受けできません。
| 商品の特徴 | ●ヘモフィルスID4 分画は発育因子を添加したブレインハートインフュージョンの4 分画平板で、X 因子、V 因子の要求性及び溶血反応でヘモフィルス属の区別に用います●生培地 | ||
|---|---|---|---|
| メーカー名 | 日本ベクトン・ディッキンソン | 入数 | 10枚入 |
| 用途 | ヘモフィルス用 | ||
| 備考 | 【返品について】お客様のご都合による返品はお受けできません。 | ||
※免責事項
本サービスでは、サイト上に最新の商品情報を表示するよう努めておりますが、メーカーの都合等により、商品規格・仕様(容量、パッケージ、原材料、原産国など)が変更される場合がございます。このため、実際にお届けする商品とサイト上の商品情報の表記が異なる場合がございますので、ご使用前には必ずお届けした商品の商品ラベルや注意書きをご確認ください。さらに詳細な商品情報が必要な場合は、製造元にお問い合わせください。
また、商品名および販売単位における「セット」や「箱」の表記は、必ずしも箱でのお届けをお約束するものではありません。
お届け形態は倉庫の在庫状況等により異なる場合がございます。あらかじめご了承ください。
お客様レビュー
投稿されたレビューはありません。お客様のレビューコメントをお待ちしております。